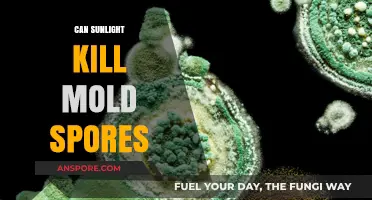
Sunlight's Power: Can Natural Light Eliminate Mold Spores Effectively?

If you're having trouble locating *Spore* on your computer, it’s likely due to a few common issues. First, ensure you’re searching in the correct folder, typically the default installation directory like *Program Files* or *Steam Library* if purchased through Steam. If the game was installed via a digital platform, check the platform’s library or installed games list. Additionally, verify if the game was accidentally uninstalled or if files were moved or deleted. Running a search for *“Spore”* in your computer’s file explorer or checking the recycle bin can also help. If all else fails, reinstalling the game from its original source or verifying its integrity through the platform’s settings might resolve the issue.
| Characteristics | Values |
|---|---|
| Issue | Unable to locate Spore game installation on computer |
| Possible Causes |
|
| Common Solutions |
|
| Platforms Affected | Windows, macOS, Linux (if applicable) |
| Related Error Messages | "Spore not found", "Game installation not detected", "Unable to locate game files" |
| Community Forums | EA Help, Steam Community, Reddit (r/spore) |
| Last Updated | May 2024 |
| Additional Notes | Ensure that the game is compatible with your operating system and meets minimum system requirements. Check for any pending updates or patches for the game or platform. |
Explore related products
What You'll Learn
- Check Downloads Folder: Search for Spore in your Downloads folder or default installation directory
- Use Search Function: Use Windows Search or Finder to locate Spore by file name
- Verify Installation Path: Confirm the installation path during setup matches your current search location
- Hidden Files Check: Enable hidden files view to ensure Spore isn’t in a hidden folder
- Reinstall Spore: If still missing, download and reinstall Spore from the original source

Check Downloads Folder: Search for Spore in your Downloads folder or default installation directory
If you’ve downloaded *Spore* but can’t locate it on your computer, the first logical step is to check your Downloads folder. This directory is the default landing spot for most files acquired from the internet, making it a prime candidate for finding the game installer. Open the folder by typing "Downloads" into your search bar or navigating to it via your file explorer. Once inside, use the search function (usually Ctrl+F on Windows or Cmd+F on Mac) and type "Spore" to quickly filter results. If the file appears, right-click and select "Show in Folder" to verify its location and proceed with installation.
Analyzing why this step is effective reveals a simple truth: users often overlook the obvious. In the rush to download and install, it’s easy to forget where files are saved, especially if your Downloads folder is cluttered. *Spore*’s installer might be buried among other files, or its name could vary slightly (e.g., *Spore_Setup.exe* or *Spore_Installer.dmg*). By systematically searching this folder, you eliminate one of the most common reasons for "missing" files. This approach is particularly useful if you’ve recently downloaded the game, as files tend to remain in the Downloads folder until moved or deleted.
For those who prefer a more structured approach, here’s a step-by-step guide: 1) Open your file explorer and navigate to the Downloads folder. 2) Use the search bar to type "Spore" and press Enter. 3) If multiple results appear, check file types (e.g., .exe, .dmg) to identify the installer. 4) If the file isn’t there, sort the folder by date to narrow down recent downloads. 5) If still unsuccessful, proceed to check the default installation directory (e.g., *Program Files* on Windows or *Applications* on Mac), as some systems may auto-install files without user intervention.
A persuasive argument for starting with the Downloads folder is its role as a temporary holding area. Most operating systems and browsers are configured to save files here by default, making it the most probable location for *Spore*’s installer. Ignoring this step could lead to unnecessary frustration, such as re-downloading the game or searching in less likely locations. By prioritizing this folder, you save time and ensure a more efficient troubleshooting process.
Finally, a comparative perspective highlights the Downloads folder’s advantage over other directories. Unlike the default installation folder, which requires knowledge of system-specific paths, the Downloads folder is universally accessible and user-friendly. It’s also less likely to be affected by permissions issues or hidden files, making it a safer starting point for users of all technical levels. In essence, checking the Downloads folder isn’t just a step—it’s a strategic move that maximizes your chances of finding *Spore* quickly and painlessly.
Are Spore-Grown Plants Harmful? Unveiling the Truth About Their Safety
You may want to see also

Use Search Function: Use Windows Search or Finder to locate Spore by file name
If you're struggling to find Spore on your computer, the built-in search functions in Windows and macOS can be your first line of defense. These tools are designed to scan your entire system for files and applications, making them ideal for locating misplaced games like Spore. Start by pressing the Windows key and typing "Spore" into the search bar on Windows, or open Finder and use the search field in the top-right corner on a Mac. This simple step often yields immediate results, especially if the game is installed in a default location.
Analyzing why this method works reveals its efficiency. Both Windows Search and Finder index files and folders, allowing them to quickly retrieve matches based on file names, extensions, or even content within files. For Spore, the search is likely to find the executable file (e.g., "SporeApp.exe" or "Spore.app") or related folders like "Electronic Arts" or "Maxis." If the game was installed in a non-default directory, this approach can save you from manually combing through drives and partitions.
However, there are caveats. If Spore was installed under a different name or if the search index is outdated, results may not appear. To mitigate this, refine your search by including file extensions (e.g., "*.exe" on Windows or "*.app" on macOS) or partial folder names. For instance, searching for "SporeApp" or "Maxis" can narrow down results. Additionally, ensure your search index is up-to-date by checking system settings—an outdated index might miss recently installed files.
A practical tip is to use advanced search operators. On Windows, enclose phrases in quotes (e.g., "Spore Game") to search for exact matches, or use wildcards like "*" to find partial matches. On macOS, combine search criteria using the "+" symbol (e.g., "Spore + kind:application") to filter results by file type. These techniques can significantly improve accuracy, especially if your system contains multiple files with similar names.
In conclusion, leveraging the search function is a straightforward yet powerful way to locate Spore on your computer. By understanding how these tools work and employing advanced techniques, you can bypass the frustration of manual searches. Whether you're on Windows or macOS, this method is a time-saving first step that often leads directly to your missing game. If it fails, it at least provides a clear indication that the issue lies elsewhere, such as an incomplete installation or a corrupted file.
Moss Spores vs. Seeds: Unraveling the Tiny Green Mysteries
You may want to see also

Verify Installation Path: Confirm the installation path during setup matches your current search location
One common oversight when troubleshooting missing game files is neglecting to verify the installation path. During the initial setup of *Spore*, the installer prompts you to choose a directory where the game files will reside. If you’ve since forgotten this location or accidentally installed it in a non-default folder, your search efforts may be futile. For instance, if you selected *D:\Games* instead of the typical *C:\Program Files (x86)\Electronic Arts*, your system’s default search locations won’t include this path, rendering the game seemingly invisible. Always cross-reference the installation logs or setup screenshots to pinpoint the exact directory chosen during installation.
To rectify this, begin by recalling or retracing your installation steps. If memory fails, check the installer’s default settings—most programs default to *C:\Program Files* or *C:\Program Files (x86)*. However, if you manually altered this during setup, the game could be tucked away in a custom folder like *Documents\My Games* or even an external drive. A practical tip: search for files with extensions like *.exe* or *.cfg* related to *Spore* using Windows Search or File Explorer, ensuring you’ve enabled “Search hidden folders and system files” for a comprehensive scan.
A comparative approach reveals that users often assume games install in default locations, but custom paths are more common than expected. For example, Steam users frequently relocate game installations to secondary drives for storage management, a practice mirrored by *Spore* players. If you’ve ever moved or reinstalled your operating system, the original installation path might no longer exist, further complicating the search. In such cases, reinstalling *Spore* while explicitly noting the chosen directory can save future headaches.
Persuasively, verifying the installation path isn’t just about finding *Spore*—it’s about adopting a systematic approach to software management. By documenting installation paths during setup, you create a reference point for future troubleshooting. Tools like *Everything Search Engine* or *WhereIsIt* can index your entire system, making it easier to locate files based on partial path recalls. Pair this with a habit of screenshotting installation steps, and you’ll transform a frustrating search into a quick, methodical process.
In conclusion, the installation path is the linchpin of locating *Spore* on your computer. Whether through memory, logs, or search tools, confirming this path bridges the gap between a missing game and a successful launch. Treat installation directories with the same care as saving important documents—a little foresight goes a long way in avoiding digital hide-and-seek.
Inhaling Spores: Uncovering the Hidden Health Risks and Causes
You may want to see also
Explore related products

Hidden Files Check: Enable hidden files view to ensure Spore isn’t in a hidden folder
If you’re struggling to locate *Spore* on your computer, one often-overlooked culprit is hidden folders. By default, operating systems like Windows, macOS, and Linux conceal certain files and directories to prevent accidental deletion or modification. Unfortunately, this can also make installed programs like *Spore* seemingly vanish. Enabling hidden files view is a straightforward yet effective step to ensure the game isn’t tucked away in one of these obscured locations.
Steps to Enable Hidden Files View:
On Windows, open File Explorer, click the "View" tab, and check the "Hidden items" box. For macOS, open Finder, press `Command + Shift + .` (period) to toggle hidden files. On Linux, the method varies by file manager; in Nautilus, for example, press `Ctrl + H`. Once enabled, navigate through directories like *Program Files*, *AppData*, or *Applications* to search for *Spore* or its associated folders.
Why This Matters:
Hidden folders often contain critical system files, but they can also house user-installed programs, especially if the installation path was customized or if the game was moved post-install. For instance, *Spore* might reside in a hidden folder within *AppData* on Windows or *Library* on macOS. Without enabling hidden files view, these locations remain invisible, making the game appear missing even if it’s installed.
Practical Tip:
After enabling hidden files view, use the search function in File Explorer or Finder to look for *Spore* or related keywords like "EA" or "Maxis." This narrows down the search and saves time. If you find the game in a hidden folder, consider creating a desktop shortcut or moving it to a more accessible location, ensuring it doesn’t disappear again.
Caution:
While exploring hidden files, avoid modifying or deleting anything unless you’re certain of its purpose. System files in hidden folders are essential for your computer’s operation, and tampering with them can cause instability. Stick to identifying *Spore* and leave other files undisturbed.
By taking this simple yet targeted approach, you can rule out hidden folders as the reason for *Spore*’s disappearance and move closer to resolving the issue. It’s a small step, but one that often yields immediate results.
Breloom's Spore Ability: Mirror Herb's Role in Learning the Move
You may want to see also

Reinstall Spore: If still missing, download and reinstall Spore from the original source
If you've exhausted all other options and still can't locate Spore on your computer, it's time to consider a fresh installation. Reinstalling the game from its original source is a straightforward solution that ensures you have the most up-to-date and complete version. This approach is particularly useful if you suspect file corruption or if the game was accidentally deleted. Here’s how to proceed: start by visiting the platform where you originally purchased Spore, such as Origin, Steam, or the EA app. Log in to your account, locate Spore in your library, and initiate the download. If you purchased a physical copy, insert the installation disc or use the provided product key to download the game from the official website. Follow the on-screen instructions to complete the installation, ensuring you have enough disk space and administrative privileges.
One common mistake users make during reinstallation is overlooking the need to uninstall any remnants of the previous installation. Before downloading Spore again, navigate to your computer’s control panel, find the "Programs and Features" section, and uninstall any existing Spore entries. Additionally, manually delete any leftover folders in the installation directory (often found in *C:\Program Files* or *C:\Program Files (x86)*). This step prevents conflicts between old and new files, ensuring a clean installation. If you’re unsure about which files to delete, use the search function in File Explorer to locate and remove any Spore-related folders or registry entries.
Reinstalling Spore isn’t just about downloading the game again—it’s also an opportunity to optimize your gaming experience. After installation, check for updates within the game launcher or platform to ensure you have the latest patches and DLCs. If you’re using a newer operating system like Windows 10 or 11, run the game in compatibility mode for Windows 7 or 8 to avoid performance issues. For users with older hardware, consider adjusting the game’s graphics settings to improve frame rates. Pro tip: if you’re reinstalling due to frequent crashes, verify the integrity of your game files through the platform’s built-in tools, such as Steam’s "Verify Integrity of Game Files" feature.
While reinstalling Spore is generally effective, it’s not without potential pitfalls. For instance, if you’ve lost access to your original purchase account or product key, you may need to contact customer support for assistance. Additionally, reinstalling doesn’t guarantee the recovery of saved games or custom content unless you’ve backed them up separately. To avoid this issue in the future, periodically back up your Spore saves (located in *Documents\My Games\Spore*) to an external drive or cloud storage. Finally, if the game still fails to launch after reinstallation, consider checking your system’s drivers, antivirus settings, or firewall permissions, as these can sometimes interfere with game execution.
In conclusion, reinstalling Spore from the original source is a reliable fix for missing or malfunctioning installations. By following a systematic approach—uninstalling remnants, downloading the game anew, and optimizing settings—you can restore the game to its full functionality. While the process may seem tedious, it’s often the most effective way to resolve persistent issues. Remember, prevention is key: keep your game files organized, back up your saves, and stay updated to minimize the need for future reinstalls. With these steps, you’ll be back to evolving your creatures and exploring galaxies in no time.
Can Mold Spores Penetrate Filter Discs? Exploring Filtration Effectiveness
You may want to see also
Frequently asked questions
Check your default installation directory, usually `C:\Program Files (x86)\Electronic Arts\SPORE` or `C:\Program Files\Electronic Arts\SPORE`. If you installed it elsewhere, search your computer for the "SporeApp.exe" file.
Try manually searching for the game executable (`SporeApp.exe`) in the installation folder. If it’s missing, reinstall the game. Alternatively, check if the game is hidden in your Start menu or taskbar settings.
Check your browser’s default download location (e.g., `Downloads` folder). If you can’t find it, search your computer for the file name (e.g., "Spore_Setup.exe"). If it’s still missing, redownload the game from a trusted source.
![Spore Creepy and Cute Parts Expansion Pack [Download]](https://m.media-amazon.com/images/I/515bVZdqUGL._AC_UY218_.jpg)
![Spore Galactic Adventures [Download]](https://m.media-amazon.com/images/I/71Sta-dtY1L._AC_UY218_.jpg)